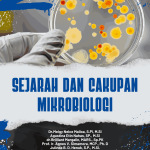

SEJARAH DAN CAKUPAN MIKROBIOLOGI
Starting: Rp50.000
Penulis :Meigy Nelce Mailoa, Agustina Etin Nahas, Brilliant Margalin, Agnes V. Simamora, Julinda B. D. Henuk, Lily Fauziah Ishaq, Angreni Beaktris Liunokas,Meigy Nelce Mailoa, Ranno Marlany Rachman, Kurniawan, Martha L Wattimena
ISBN : 978-623-8722-02-0
Description
Reviews (0)
Description
| SKU | N/A |
|---|---|
| Category | Mikrobiologi |
Buku ini berisikan bahasan tentang Sejarah dan Cakupan Mikrobiologi, Struktur dan Fungsi Penyusun Sel Prokariotik dan Eukariotik, Karekteristik Bakteri dan Jamur, Karakteristik Protozoa dan Mikroalga, Karakteristik Virus, Media Pertumbuhan dan Pertumbuhan Mikroba, Nutrien Mekanisme Transpor Nutrien, Metabolisme Mikroba, Genetika Sitematika Mikroba dan Rekayasa Genetika, Aplikasi Mikroorganisme serta Biosintesis Mikromolekul.
ISBN : 978-623-8722-02-0
Reviews (0)
Leave a Reply

Reviews
There are no reviews yet.